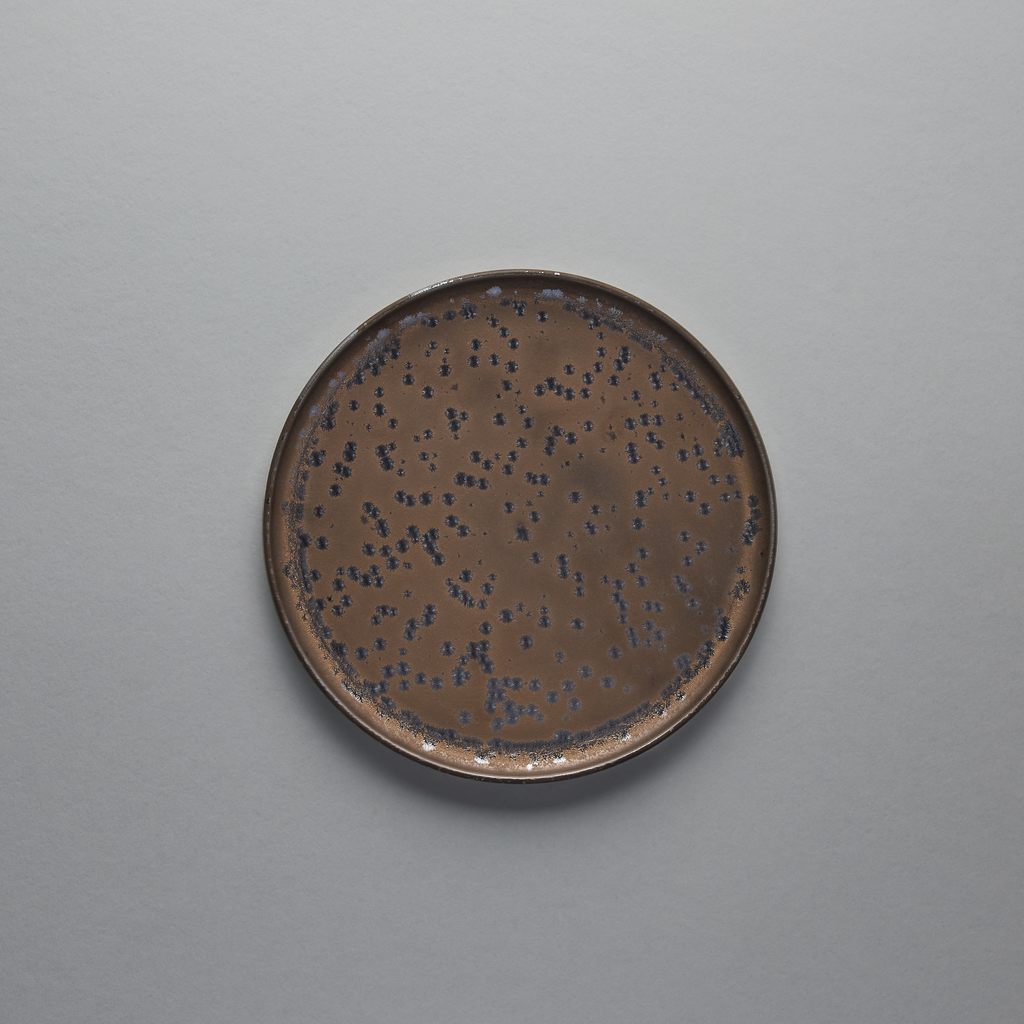

Kinrei Short Rim Plate 22.9cm, 22.9cm x 1.7cm
$75.00
(
/
)
Unavailable
Timeless and modern. This refined and minimalistic plate will bring out the best in all your meals.
Finishing: Matte with Shimmer
Care instructions:
Made for everyday use, all the pieces from this collection are dishwasher safe, top-rack recommended.
SKU:
450-2-676